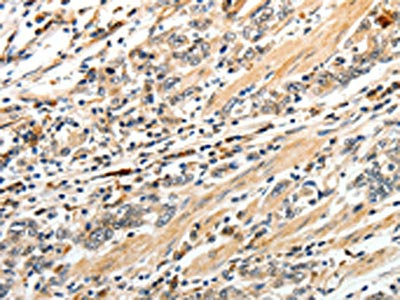

CD93 Antibody
-
中文名稱:CD93兔多克隆抗體
-
貨號:CSB-PA205301
-
規(guī)格:¥1100
-
圖片:
-
The image on the left is immunohistochemistry of paraffin-embedded Human cervical cancer tissue using CSB-PA205301(CD93 Antibody) at dilution 1/50, on the right is treated with synthetic peptide. (Original magnification: ×200)
-
The image on the left is immunohistochemistry of paraffin-embedded Human gastric cancer tissue using CSB-PA205301(CD93 Antibody) at dilution 1/50, on the right is treated with synthetic peptide. (Original magnification: ×200)
-
-
其他:
產(chǎn)品詳情
-
Uniprot No.:
-
基因名:
-
別名:C1q receptor 1 antibody; C1q/MBL/SPA receptor antibody; C1qR antibody; C1qR(p) antibody; C1qr1 antibody; C1QR1_HUMAN antibody; C1qRp antibody; CD93 antibody; CD93 antigen antibody; CD93 molecule antibody; CDw93 antibody; Complement component 1 q subcomponent receptor 1 antibody; Complement component C1q receptor antibody; dJ737E23.1 antibody; ECSM3 antibody; Matrix remodeling associated protein 4 antibody; Matrix remodelling associated 4 antibody; Matrix-remodeling-associated protein 4 antibody; MXRA4 antibody
-
宿主:Rabbit
-
反應(yīng)種屬:Human,Mouse,Rat
-
免疫原:Synthetic peptide of Human CD93
-
免疫原種屬:Homo sapiens (Human)
-
標記方式:Non-conjugated
-
抗體亞型:IgG
-
純化方式:Antigen affinity purification
-
濃度:It differs from different batches. Please contact us to confirm it.
-
保存緩沖液:-20°C, pH7.4 PBS, 0.05% NaN3, 40% Glycerol
-
產(chǎn)品提供形式:Liquid
-
應(yīng)用范圍:ELISA,IHC
-
推薦稀釋比:
Application Recommended Dilution ELISA 1:3000-1:10000 IHC 1:50-1:200 -
Protocols:
-
儲存條件:Upon receipt, store at -20°C or -80°C. Avoid repeated freeze.
-
貨期:Basically, we can dispatch the products out in 1-3 working days after receiving your orders. Delivery time maybe differs from different purchasing way or location, please kindly consult your local distributors for specific delivery time.
-
用途:For Research Use Only. Not for use in diagnostic or therapeutic procedures.
相關(guān)產(chǎn)品
靶點詳情
-
功能:Receptor (or element of a larger receptor complex) for C1q, mannose-binding lectin (MBL2) and pulmonary surfactant protein A (SPA). May mediate the enhancement of phagocytosis in monocytes and macrophages upon interaction with soluble defense collagens. May play a role in intercellular adhesion.
-
基因功能參考文獻:
- Report increased CD93 expression in patients with chronic plaque psoriasis and propose the C allele of rs2749817 as a new risk allele for psoriasis. PMID: 28421233
- Results show that CD93 and MMRN2 are co-expressed in the blood vessels of various tumors and their interaction modulates the angiogenic process. PMID: 28912033
- These findings identify novel protein interactions involving CLEC14A, CD93 and CD248 with MMRN2 as targetable components of vessel formation PMID: 28671670
- CD93 and Other Plasma Cell Survival Factor Genes Associated with Measles-Specific Antibody Response after Vaccination PMID: 27529750
- Soluble expression of disulfide-bonded C-type lectin like domain of human CD93 in the cytoplasm of Escherichia coli. The recombinant protein could alter LPS pro-inflammatory activity on THP1 cells. PMID: 27742562
- Vascular CD93 expression is elevated in nasopharyngeal carcinoma and is correlated with T classification, N classification, distant metastasis, clinical stage and poor prognosis (all P < 0.05). In addition, overexpression of CD93 promoted angiogenesis in vitro. PMID: 27255994
- both transmembrane and soluble CD93 are overexpressed in patients with neovascular Age-Related Macular Degeneration. PMID: 27859225
- Elevated serum sCD93 levels reflected exacerbated status of allergic diseases, including CSU [chronic spontaneous urticaria ], AR[allergic rhinitis], and asthma. ICS [inhaled corticosteroid] use significantly diminished serum sCD93 levels in steroid-naive patients with BA[Bronchial asthma]. This result may suggest sCD93 in serum as a therapeutic marker for allergic inflammation. PMID: 28332366
- Data show that CD93 antigen proved to be phosphorylated on tyrosine 628 and 644 following cell adhesion on laminin through dystroglycan. PMID: 26848865
- CD93 expression identifies a predominantly cycling, non-quiescent leukemia-initiating cell population in MLL-rearranged AML, providing opportunities for selective targeting and eradication of LSCs. PMID: 26387756
- The T/T genotype of SNP rs2749817 of CD93 is associated with disseminated cancer. PMID: 26008729
- CD93 is a key regulator of glioma angiogenesis and vascular function, acting via cytoskeletal rearrangements required for cell-cell and cell-matrix adhesion. PMID: 26363010
- These data support a mechanism whereby gC1qR plays an important role in HPV-16 E2-induced human cervical squamous carcinoma cell apoptosis via a mitochondria-dependent pathway. PMID: 25288439
- The data indicate that gC1qR inhibits viability, migration and proliferation of cervical squamous cells carcinoma via the p38 MAPK signalling pathway. PMID: 23052251
- Antibody-dependent enhancement of parvovirus B19 involves an alternative mechanism mediated by the heat-sensitive complement factor C1q and its receptor, CD93. PMID: 24807719
- Expression of CD93 on the lymphocyte population of peripheral blood cells from infants at 1 month after birth was also significantly decreased, compared with that for neonatal umbilical cord blood. PMID: 24033555
- HPV 16 E2 induces apoptosis by silencing the gC1qR gene or inhibiting p38 MAPK/JNK signalling in cervical squamous cell carcinoma PMID: 23651874
- These data support a mechanism whereby gC1qR induces apoptosis through the mitochondrial and p53-dependent pathways in cervical squamous cell carcinoma. PMID: 23268996
- soluble EGF-like domain containing CD93 protein is a novel angiogenic factor acting on the endothelium PMID: 23272129
- [review] Following a comprehensive summary of CD93 expression patterns, this review focuses on recent findings that address the putative function of CD93 in inflammation and innate immunity. PMID: 22206251
- Data show that Pic, a class 2 SPATE protein produced by Shigella flexneri 2a targets a broad range of human leukocyte glycoproteins including CD43, CD44, CD45, CD93, CD162 and the surface-attached chemokine fractalkine. PMID: 21768350
- Results suggest that the plasma concentration of soluble CD93 is a potential novel biomarker for Coronary Artery Disease (CAD), including MI. PMID: 21332844
- expression on naive T lymphocytes (CD4(+)CD45RA (+) cells) in human neonatal umbilical cord blood PMID: 20512406
- both B1 receptor and gC1q receptor are involved in the vascular leakage induced by hereditary and acquired angioedema plasma. PMID: 19796797
- To clarify the cellular and molecular properties of C1qRp it has been demonstrated that C1q does not show enhanced binding to C1qRp-transfected cells, is not a receptor for C1q, and is identical to CD93 with functions relevant to intercellular adhesion. PMID: 11994479
- C1qRp defines a new human stem cell population with hematopoietic and hepatic potential PMID: 12140365
- O-glycosylation is important in the stable cell surface expression of C1qRP/CD93 PMID: 12891708
- Taken together, these findings indicate that the expression of the CD93 molecule identified by CD93 mAb (mNI-11) is dramatically decreased on U937 cells with apoptotic properties PMID: 18094537
- RNAi-mediated suppression of gC1qR/p32 markedly reduced HTNV binding and infection in human lung epithelial A549 cells PMID: 18834607
顯示更多
收起更多
-
亞細胞定位:Membrane; Single-pass type I membrane protein.
-
組織特異性:Highly expressed in endothelial cells, platelets, cells of myeloid origin, such as monocytes and neutrophils. Not expressed in cells of lymphoid origin.
-
數(shù)據(jù)庫鏈接:
Most popular with customers
-
-
YWHAB Recombinant Monoclonal Antibody
Applications: ELISA, WB, IHC, IF, FC
Species Reactivity: Human, Mouse, Rat
-
Phospho-YAP1 (S127) Recombinant Monoclonal Antibody
Applications: ELISA, WB, IHC
Species Reactivity: Human
-
-
-
-
-